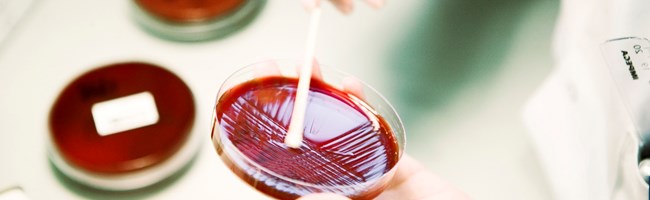

Sundhed og sygdom ved oversvømmelser
Spildevand indeholder sygdomsfremkaldende bakterier, så derfor skal man iføre sig værnemidler, før man går i gang med oprydningsarbejdet ellers skal man afvente professionel assistance.
Sundhedsstyrelsen har retningslinjer på deres hjemmeside, og vil også informere i medierne ved større vandskader. Hvis der er spildevand indblandet, skal der - efter det umiddelbare oprydningsarbejde - udføres en specialrengøring.
Se Sundhedsstyrelsens retningslinjer her.
I denne folder kan du se mere om hvordan bakterieniveauet ændres efter et skybrud der har medført oversvømmelser i kældre.